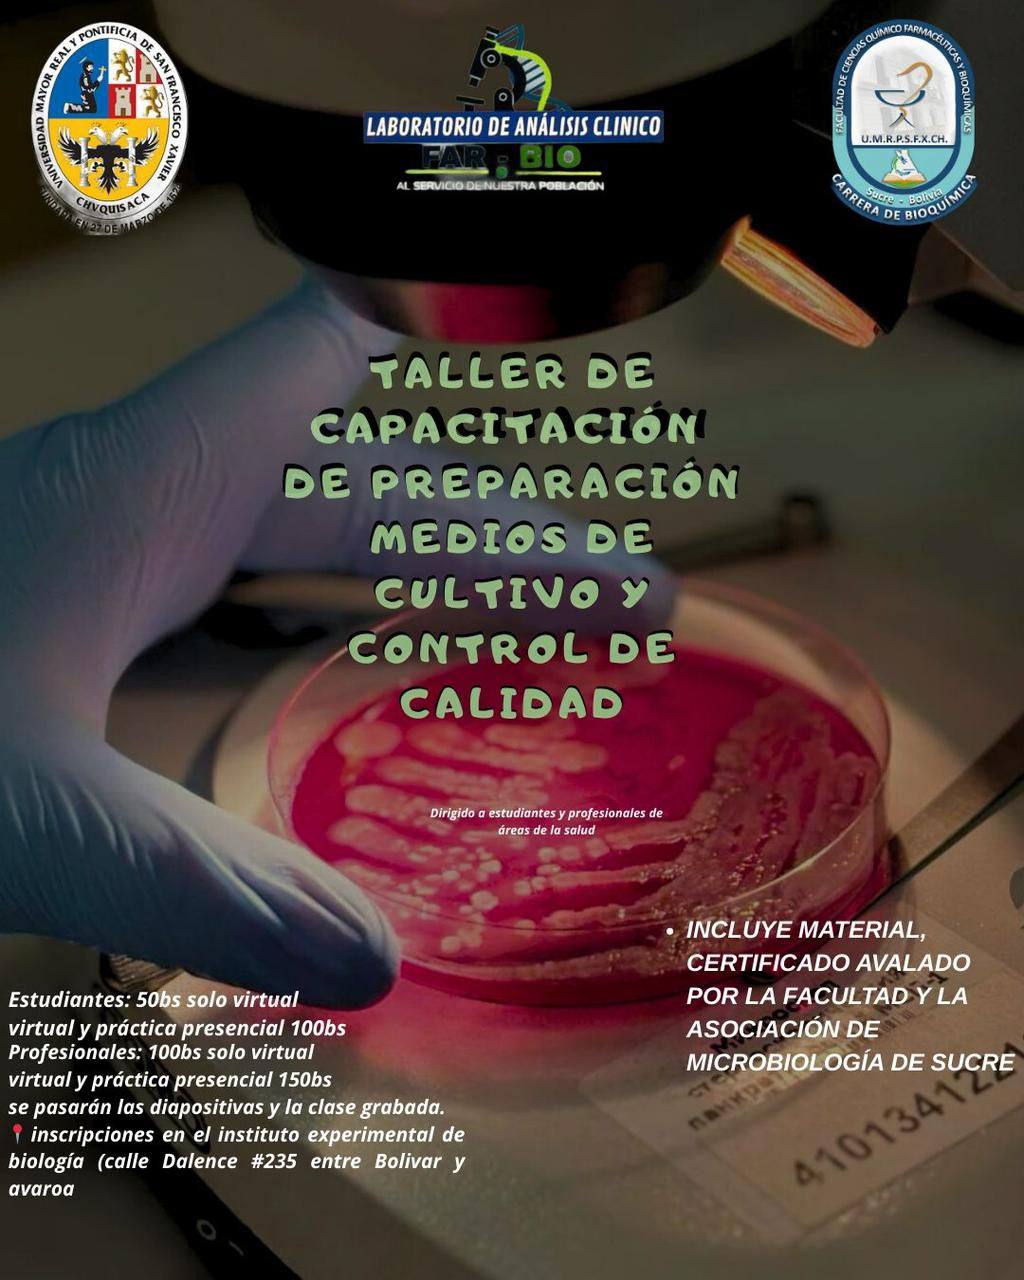

La Facultad de Ciencias Químico Farmacéuticas y Bioquímicas, a través del Laboratorio de Análisis Clínico, invita a participar en el Taller de Capacitación en Preparación de Medios de Cultivo y Control de Calidad, dirigido a estudiantes y profesionales del área de la salud.
El taller contará con modalidad virtual y presencial, e incluye material de apoyo, así como certificado avalado por la Facultad y la Asociación de Microbiología de Sucre.
Costos de participación:
-
Estudiantes: 50 Bs (virtual) | 100 Bs (virtual + práctica presencial)
-
Profesionales: 100 Bs (virtual) | 150 Bs (virtual + práctica presencial)
📍 Inscripciones: Instituto Experimental de Biología (Calle Dalence N° 235, entre Bolívar y Avaroa).
💻 Se entregará material digital, diapositivas y clase grabada.
La Facultad reafirma su compromiso con la formación académica y la actualización profesional de calidad.

